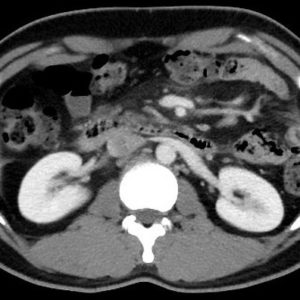
Viêm mỡ mạc treo

TIÊU HOÁ
Hiển thị 1161–1180 của 1445 kết quảĐã sắp xếp theo mới nhất
-

Nhồi máu mạc nối
Lượt xem: 202» 22-11-2018 -

Nhồi máu mạc nối
Lượt xem: 243» 22-11-2018 -

Nhồi máu mạc nối
Lượt xem: 844» 22-11-2018 -

Nhồi máu mạc nối
Lượt xem: 235» 22-11-2018 -

Nhồi máu mạc nối
Lượt xem: 240» 22-11-2018 -

Viêm mỡ mạc treo
Lượt xem: 257» 21-11-2018 -

Chấn thương lách
Lượt xem: 179» 21-11-2018 -

Viêm túi mật cấp
Lượt xem: 168» 21-11-2018 -

Vỡ lách
Lượt xem: 216» 21-11-2018 -

Hội chứng Budd Chiari
Lượt xem: 215» 21-11-2018 -

Túi thừa dạ dày
Lượt xem: 677» 21-11-2018 -

Lồng ruột
Lượt xem: 569» 20-11-2018 -

Lymphoma ruột non
Lượt xem: 633» 20-11-2018 -

Viêm bờm mỡ đại tràng
Lượt xem: 552» 20-11-2018 -

Túi thừa túi mật
Lượt xem: 608» 20-11-2018 -

Túi thừa thực quản
Lượt xem: 599» 19-11-2018 -

Dị vật ống tiêu hóa
Lượt xem: 138» 19-11-2018 -

U ruột non
Lượt xem: 570» 19-11-2018 -

U thực quản
Lượt xem: 185» 18-11-2018 -

Viêm túi mật cấp
Lượt xem: 580» 18-11-2018